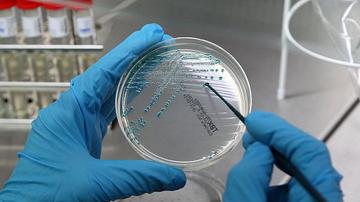
V boj s

Gonoreja je bolezen, ki lahko okuži genitalije, danko in grlo, okužba slednjega pa najbolj skrbi zdravstvene strokovnjake, poroča BBC. Kombinacija oralnega seksa in upada uporabe kondomov namreč najbolj pripomoreta k širjenju na praktično vsa zdravila odporne gonoreje, poleg tega pa bi uporaba antibiotikov lahko privedla do tega, da bi odpornost nanje razvile tudi bakterije, ki so sorodnice gonoreje in so v zadnjem delu grla.
"Ko uporabite antibiotike za zdravljenje okužb, kot je npr. navadno vneto grlo, se ti pomešajo z bakterijami rodu Neisseria (gre za zelo velik rod bakterij, patogeni pa sta samo dve vrsti, in sicer N. meningitidis in N. gonorrhoeae) v vašem grlu in to privede do odpornosti," je pojasnila Teodora Wi s Svetovne zdravstvene organizacije (WHO).
In položaj je že precej zaskrbljujoč, svarijo strokovnjaki, saj bakterija hitro pridobiva odpornost. Po podatkih WHO-ja iz analize 77 držav je razvidno, da je odpornost široko razširjena, trije primeri iz Japonske, Francije in Španije pa so bili popolnoma neozdravljivi. WHO dodatno skrbi podatek, da je večina okužb v manj razvitih predelih sveta, kjer je težje nadzorovati, kako odporna je bakterija dejansko postala.
Novih zdravil ni
Celotnemu položaju pa svoje doda še dejstvo, da se trenutno razvijajo zgolj trije kandidati za nove antibiotike in prav nobenih zagotovil ni, da bodo tudi ugledali trg, pravi Manica Balasegaram, ki sodeluje v Globalnem partnerstvu za raziskave in razvoj antibiotikov. Zato WHO ocenjuje, da bo na koncu treba razviti cepivo proti gonoreji, saj trenutno po besedah Richarda Stablerja z London School of Hygiene and Tropical Medicine že uporabljamo zdravila, ki so bila mišljena zgolj kot izhod v sili.
Z gonorejo se okuži 78 milijonov ljudi letno, prenaša se prek oralnih, vaginalnih in analnih spolnih odnosov, okužba pa lahko povzroča neplodnost, medenično vnetje in se med nosečnostjo lahko prenaša tudi na otroke. Simptomi vključujejo gost zelen ali rumen izcedek iz genitalij, bolečino pri uriniranju in krvavenje v vmesnem času med dvema menstrualnima cikloma.

Komentarji so trenutno privzeto izklopljeni. V nastavitvah si jih lahko omogočite. Za prikaz možnosti nastavitev kliknite na ikono vašega profila v zgornjem desnem kotu zaslona.
Prikaži komentarje